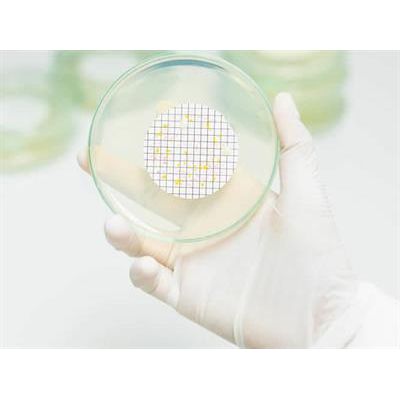

- Home
- Companies
- Focus Laboratories Inc.
- Products
- Focus - Aerobic and Yeast and Mold ...
Focus - Aerobic and Yeast and Mold Plate Count
10 gm of sample is diluted with a pH balanced, isotonic diluent, usually supplemented with chemical neutralizers for any antimicrobial agents which might be present in the drug product, and further homogenized by shaking, stomaching, vortexing or other means.
The use of neutralizing agents is important and must be validated. Pharmaceutical products are often preserved with parabens, aldehydes or quaternary ammonium compounds. Or the drug substance itself may be inherently antimicrobial. If these antimicrobial agents are diluted with the product and placed in agar plates, they will inhibit any microbes which might be present from replicating and thereby prevent them from growing into visible colony forming units.
USP <61> lists several potential neutralizing agents, based on the offending interfering substance. The most widely used compounds are lecithin and polysorbate 80. This combination of neutralizers will typically inactivate most quats, parabens, iodine, and bisbiguanides. See the Neutralization section for more information.
Once the sample is homogenized in a diluent, serial dilutions are prepared to approximate the count. 1 mL of dilutions are placed in petri plates, in duplicate. Sterile nutrient agar which has been tempered to about 45°C is poured over the dilution in the petri plate and the petri plate is swirled to thoroughly disperse the product and any bioburden therein. Once the agar hardens the plate is inverted and placed in a 30 – 35C incubator for aerobic plate count, and 20 – 25°C incubator for yeast and mold count. Inversion of the plates prevents condensation from the lids dropping on the agar surface and artificially spreading colony forming units.
At the end of the incubation period, the plates are removed and the colony forming units are counted. For samples with a high bioburden, the dilution which represents 30 – 300 colonies are counted. FOCUS plates all dilutions in duplicate, so the average of the two plates is calculated, and the count is multiplied by the dilution factor. In other words, if an average of 72 colonies was counted on duplicate 10-2 plates, a count of 7200 cfu/gm of product would be reported for that plate count. All this for $30!
- Spread Plate
As above but rather than plating, diluent with product and microbes are passed through a 0.45 micron filter, capturing microbes while allowing diluent and product to pass through. Filter is placed on nutrient agar plates, and microbes growth to visible colony forming units.
